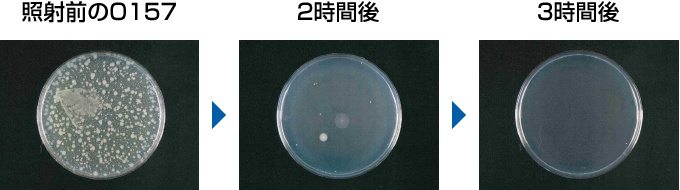
O157 | DAIKINストリーマ研究所 | ダイキン工業株式会社

マイストア
変更
お店で受け取る
(送料無料)
配送する
納期目安:
2025.12.22 16:4頃のお届け予定です。
決済方法が、クレジット、代金引換の場合に限ります。その他の決済方法の場合はこちらをご確認ください。
※土・日・祝日の注文の場合や在庫状況によって、商品のお届けにお時間をいただく場合がございます。
中毒研究 開催概要 | 第47回日本中毒学会総会・学術集会の詳細情報
開催概要 | 第47回日本中毒学会総会・学術集会。Viability/Cytotoxicity Multiplex Assay Kit CK17 取扱説明書 | DOJINDO。Viability/Cytotoxicity Multiplex Assay Kit CK17 取扱説明書 | DOJINDO。商品の説明はありません購入前にコメント下さい。O157の顕微鏡観察 : 分析計測機器(分析装置) 島津製作所。発送が1-2日で間に合わない事もあるため。口腔内科学。
ベストセラーランキングです
近くの売り場の商品
カスタマーレビュー
オススメ度 4.8点
現在、6988件のレビューが投稿されています。